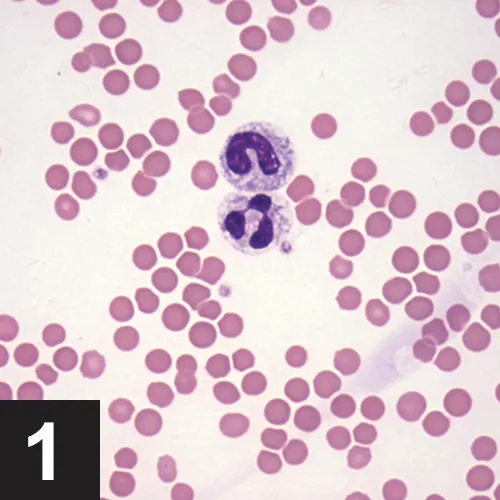
Featured Image
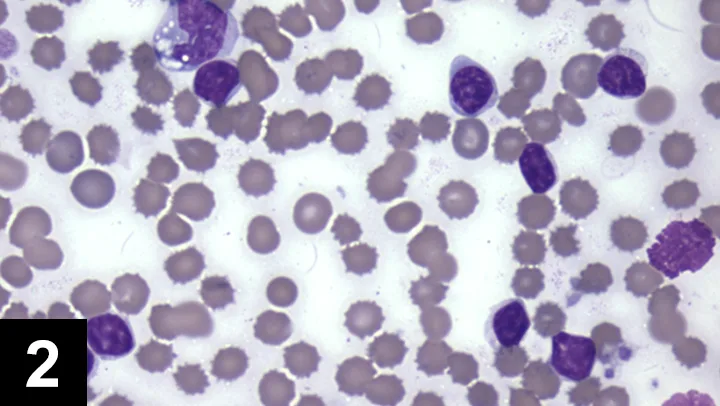

Top 5 Leukogram Patterns
Sarah Schmidt, DVM, DACVP (Clinical Pathology)*, Ashland, Massachusetts

A CBC is often completed as part of the minimum database. When the CBC is performed with an in-house hematology analyzer, a blood smear evaluation should be pursued as well to verify automated results, including confirmation of white blood cell (WBC) differential and evaluation for atypical cells, such as mast cells, blasts, and nucleated red blood cells. Following confirmation of automated results, evaluation of the leukogram, which includes total WBC count, absolute values of individual leukocytes, and leukocyte morphology, should be performed to identify any pattern. When evaluating WBC differentials, absolute cell numbers (WBC count × leukocyte %) should be interpreted as opposed to leukocyte percentage only.
1. Stress Leukogram
A stress leukogram is characterized by neutrophilia, lymphopenia, eosinopenia, and potentially monocytosis.1 It occurs primarily in dogs. The term stress denotes the presence of increased cortisol released from the adrenal gland secondary to severe disease (eg, diabetic ketoacidosis, renal failure), high body temperature, pain, dehydration, or hyperadrenocorticism.1
Neutrophilia occurs because of increased release of mature neutrophils from the bone marrow storage pool to circulating blood and decreased movement of neutrophils from circulating blood to tissue.
Lymphopenia results from retention of lymphocytes in lymphoid organs and lymphocyte lysis.
Eosinopenia is caused by decreased release of eosinophils from the bone marrow and increased lysis.
Lymphopenia is the hallmark of a stress leukogram. While the degree of neutrophilia may decrease over time, lymphopenia and often eosinopenia will persist as long as plasma concentrations of steroid hormones are increased.
Monocytosis is often found in dogs because of movement of monocytes from the marginating to circulating pool. Monocytosis can be variably found in feline stress leukograms.
A stress leukogram may also be seen following administration of exogenous glucocorticoids. A single dose of glucocorticoids may result in a stress leukogram lasting for approximately 24 hours; glucocorticoids administered for longer than 10 days may result in a stress leukogram that persists for 2–3 days after the drug is discontinued.2 The magnitude of the neutrophilia is usually up to twice the upper limit of the normal reference interval.
2. Inflammatory Leukogram
An inflammatory leukogram may be characterized by neutrophilia, or in some instances neutropenia, with or without a left shift or toxic change. Inflammatory mediators result in the release of neutrophils from the bone marrow storage pool to the circulation, and an increased rate of bone marrow neutrophil production, with or without the presence of a left shift and toxic change. Following stimulation of the bone marrow by inflammatory mediators, it takes approximately 2 to 5 days for maturation and release of neutrophils.
A left shift indicates that immature (nonsegmented) neutrophils have been released from the bone marrow into circulation prior to maturation to segmented cells.
Toxic change includes Dohle bodies (pale blue irregularly shaped cytoplasmic inclusions), increased cytoplasmic basophilia, and foamy/vacuolated cytoplasm. Toxic change indicates accelerated production of neutrophils by the bone marrow (Figure 1).
A toxic band neutrophil is found at the top of the image above a toxic segmented neutrophil. Both cells have increased cytoplasmic basophilia and foamy cytoplasm. (Modified Wright’s stain, 50× original magnification)
In general, as the left shift or degree of toxic change increases, so does the severity of the underlying inflammatory process.
While neutrophils are emerging from the bone marrow, circulating neutrophils are migrating to the source of the inflammation. The presence of a neutrophilia vs neutropenia depends on the balance between neutrophil production and increased tissue demand.
Inflammatory diseases include infectious causes (bacterial, fungal, viral, protozoal), immune-mediated diseases (immune-mediated hemolytic anemia, polyarthritis), and tissue necrosis. Many inflammatory diseases result in a neutrophilia that is 2 to 10 times the upper limit of the normal reference interval.
Other diseases in which the infection is isolated, such as a walled-off abscess, may result in a marked neutrophilia because production and release from bone marrow is high but tissue consumption of circulating neutrophils is low as the cells cannot easily infiltrate the lesion.1
After the source of the inflammation is removed (eg, infected uterus), neutrophilia may persist for 2–5 days because earlier stimulated neutrophil precursors will continue with maturation and the source of tissue consumption no longer exists.
3. Persistent Lymphocytosis (of Mature Lymphocytes)
As lymphocytes may transiently increase following excitement or exercise secondary to epinephrine, a lymphocytosis should be verified by a repeat CBC. A review of the blood smear is indicated if the lymphocytosis is persistent, as differentials will be dependent on lymphocyte morphology (small, mature lymphocytes vs lymphoblasts) (Figures 2 and 3).
The majority of the leukocytes are small lymphocytes with condensed chromatin. A vacuolated monocyte is present at the top left of the image. Two broken cells are present at the right side of the image. (Modified Wright’s stain, 50× original magnification)

The leukocytes are blast cells, most suggestive of lymphoblasts. The cells are approximately 12–15 µm in diameter with immature chromatin and variably distinct nucleoli. (Modified Wright’s stain, 50× original magnification)
Persistently increased numbers of small to intermediate lymphocytes with condensed (mature) chromatin can be the result of a neoplastic lymphocytosis or a nonneoplastic lymphocytosis.
Chronic lymphocytic leukemia (CLL) is a type of neoplastic lymphocytosis in which lymphocytes appear small to intermediate in size and have condensed chromatin. The absolute lymphocyte count for CLL can be vary between 6000/µL and 8000/µL in dogs and cats, respectively, to greater than 150,000/µL.3
Lymphocyte counts greater than 20,000–30,000/µL are generally more worrisome for CLL than for nonneoplastic conditions, although some overlap may occur.
Causes for nonneoplastic lymphocytosis include diseases that result in immune stimulation, including Ehrlichia canis infections in dogs, feline leukemia/feline immunodeficiency virus infection in cats, and Mycoplasma felis infection in cats.2,3
Thymoma and hypoadrenocorticism are differentials for dogs and cats. Hyperthyroidism and immune-mediated hemolytic anemia are additional differentials for cats. Flow cytometry of a fresh blood sample (ideally within 2 days) can greatly aid in determining a neoplastic lymphocytosis from a nonneoplastic lymphocytosis. The presence of blast cells should be reviewed by a clinical pathologist.
4. Neutropenia
Neutropenia can be caused by increased consumption of recently released and circulating mature segmented cells, decreased production, and immune-mediated destruction. Increased consumption can result from severe inflammatory disease, bacterial infections, or endotoxemia. Decreased production can result from insult to myeloid precursor cells from drugs or toxins or replacement of myeloid precursors by neoplastic cells. Immune-mediated destruction is suspected when other causes of neutropenia have been ruled out and the patient responds to immunosuppressive drugs.
The cause for neutropenia may be multifactorial as seen in parvovirus infections, in which the virus attacks rapidly dividing myeloid precursor cells and compromises gastrointestinal integrity, resulting in endotoxemia, as well as feline leukemia virus infections that can damage hematopoietic precursor cells and lead to secondary infections that consume circulating neutrophils.4,5
5. Eosinophilia
Increased bone marrow production of eosinophils is most commonly the result of parasite antigens or allergens. Parasites commonly associated with eosinophilia are those found within tissues including Dirofilaria immitis, Aelurostrongylus abstrusus, Toxocara spp, Toxascaris leonina, Ancylostoma caninum, A braziliense, A tubaeforme, and Uncinaria stenocephala. Blood cell parasites, including Mycoplasma spp, Babesia spp, and Cytauxzoon spp, do not typically result in an eosinophilia. Hypersensitivity reactions secondary to cutaneous allergens such as flea saliva are commonly associated with eosinophilia, whereas hypersensitivity reactions to inhaled allergens (atopic dermatitis) are generally not.6
Eosinophilia has also been reported with generalized inflammation (including bacterial infections) of tissues rich in mast cells, including the lungs, intestinal tract, skin, and genitourinary tract. Reported eosinophil counts that have been associated with various diseases affecting these tissues range from 2000–21,000/µL with a median value of generally less than 7000/µL.6
Hypoadrenocorticism (Addison’s disease) is another consideration for eosinophilia and has been associated with eosinophil counts of 2000–4000 µL.
Idiopathic hypereosinophilic syndrome, which is characterized by eosinophil tissue infiltration, circulating granulocytes with mature morphologic features, and lack of anemia or thrombocytopenia is strongly considered with eosinophil counts greater than 20,000 µL.
Conclusion
Evaluation of the leukogram pattern can aid in formulating differential diagnoses.
* At the time of publication, Dr. Schmidt worked with IDEXX. At the time of article creation, Dr. Schmidt was an independent contractor.